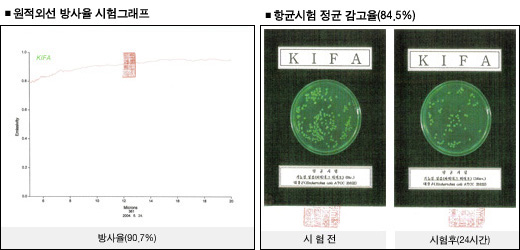

|
Á¦¸ñ
|
ÀÏǰÇâ±Õ¹ÙÀÌ¿ÀÅ×Å©Çʸ§
|
 |
| |
|
(ÁÖ)»óÁøÀÇ Áö¼ÓÀûÀÎ ¿¬±¸ °³¹ßÀÇ °á°ú·Î ÃëµæÇÑ ±¹³» ÃÖÃÊ ¹æ¸í ƯÇã [³ó¾÷¿ë ºñ´ÒÇϿ콺ÀÇ ´ÙÃþÇʸ§ Á¦Á¶ ¹æ¹ý(ƯÇã Á¦ 0406022È£)]·Î Á¦Á¶µÈ Ư¼ö Çʸ§À¸·Î½á »ýü¿¡ ÁÁÀº ¿øÀû¿Ü¼±ÀÌ ¹æ»çµÇ¸ç, ¾ß°£¿¡ º¸¿Â·ÂÀÇ À¯Áö È¿°ú°¡ Ź¿ùÇÏ¿© ÀÛ¹°ÀÇ »ýÀ°ÃËÁø ¹× °ú½ÇÀÇ ´çµµ¿Í ¿µ¾çºÐÀÇ ³óÃàÀ» Áõ°¡½ÃÄÑ ÁÝ´Ï´Ù. |
|
|
|
|
Ư¡ |
|
| |
|
1. ¿øÀû¿Ü¼±ÀÌ ¹æ»çµÇ¾î »ý¹°Ã¼ÀÇ ½ÅÁø´ë»ç ¹× ÃËÁø ¹× ³ëÈ ¹æÁö¿¡ È¿°ú°¡ ÀÖ½À´Ï´Ù. |
|
2. º¸¿Â·ÂÀÌ Å¹¿ùÇÏ¿© °Ü¿ïö ÀÛ¹°ÀÇ ³ÃÇØ¸¦ ¿¹¹æÇÒ ¼ö ÀÖ½À´Ï´Ù. |
|
3. ÀÛ¹°ÀÇ ±¤Ç鼺 ÀÛ¿ëÀ» ÃËÁø½ÃŰ¹Ç·Î °¡¿Â Ã˼º Àç¹è ÀÛ¹°¿¡ Ź¿ùÇÑ È¿°ú°¡ ÀÖ½À´Ï´Ù. |
|
4. Çʸ§ÀÇ ³»ºÎ¿¡ ÇÔÀ¯µÈ Ư¼ö ¼ººÐÀ¸·Î ÀÎÇØ ¾È°³ ¹ß»ýÀ» ¾ïÁ¦½ÃÄÑ º´ÃæÇØÀÇ ÇÇÇØ¸¦ ÁÙÀ̰í ÇϿ콺 ³»ÀÇ È¯°æÀ» ÄèÀûÇÏ°Ô ¸¸µé¾î Àå½Ã°£ ÀÏÇÒ ¼ö ÀÖ´Â ºÐÀ§±â¸¦ Á¶¼ºÇØ ÁÖ´Â ÀÎü¿¡ Ä£ÈÀûÀÎ Çʸ§ÀÔ´Ï´Ù. |
|
|
»ç¿ë¹æ¹ý ¹× ÁÖÀÇ»çÇ× |
|
| |
|
1. ¹Ýµå½Ã Çʸ§¿¡ ÀμâµÈ ±ÛÀÚ°¡ ÇϿ콺ÀÇ ¹Û¿¡¼ ºÃÀ» ¶§ ¹Ù·Î ÀÐÇôÁöµµ·Ï ¼³Ä¡ÇϽʽÿÀ. |
|
2. Çʸ§À» ¼³Ä¡ÇÒ ¶§ ÁÖ¸§ÀÌ »ý±âÁö ¾Êµµ·Ï Àû´çÈ÷ Àâ¾Æ´ç°Ü Áֽðí, ¹êµå´Â ´À½¼ÇÏ°Ô ¸Å¾îÁֽʽÿÀ. |
|
3. Ç×±ÕÁ¦¿Í ¹æ¹«Á¦´Â À¯Àû±â´ÉÀÌ ÀÖÀ» ¶§±îÁö ±× È¿´ÉÀ» ¹ßÈÖÇÕ´Ï´Ù. |
|
4. Ç×±ÕÈ¿°ú´Â ÇϿ콺³»ÀÇ ½Àµµ¿¡ µû¶ó ´Þ¶óÁú ¼ö ÀÖ½À´Ï´Ù. |
|
|
|
| |
ÀÛ¿ëÀÛ¹° |
°úä·ù(µþ±â,Âü¿Ü,¼ö¹Ú,Å丶Åä,¸á·Ð), Ư¼öÀÛ¹° |
| |
 |
| |
|
|
|
|
|
|
|
|